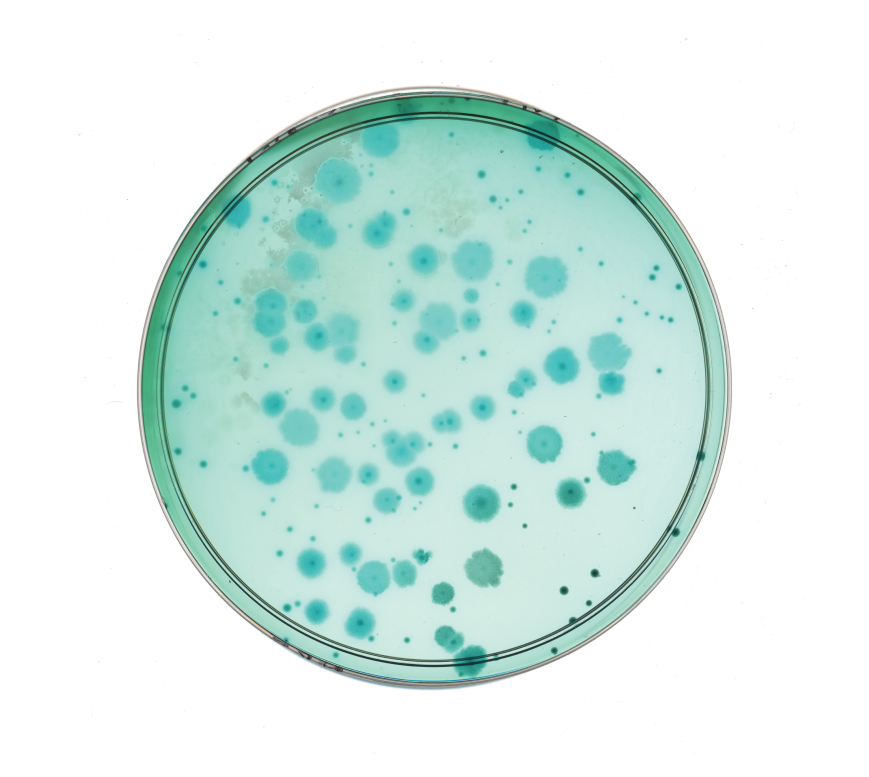
Petri dish with blue bacterial colonies growing on agar medium

The vagina is so much more than a reproductive organ—it’s a living shield, a vital health metric, a pleasure and arousal center, and a mesmerizing microbial landscape that we’re just starting to explore.
Your vagina is as mysterious and mesmerizing as the ocean. Much like the depths of the sea, we’ve barely scratched the surface of the more than 10,000,000,000 (that’s ten billion) bacteria, fungi, and other microscopic organisms that currently traverse it.1,2
This enigmatic ecosystem is constantly changing with your hormones, your genetic makeup, and your lifestyle. When ebbing and flowing in synch, its microbiota act as a first line of defense against genital and urinary tract infections, bacterial vaginosis (BV), infertility, pregnancy loss, and even some cancers.3,4,5,6,7
Clearly, the vagina is so much more than a reproductive organ—it’s a living shield, a vital health metric, a pleasure and arousal center, and a landscape worthy of increasing study. Let’s submerge into the depths of the vaginal microbiome to explore what it is, how it functions, and how to protect yours.
Definitions
Vaginal microbiome
Definitions
Vaginal microbiome: An ecosystem of bacteria, fungi, and other microscopic organisms that help protect the vaginal environment from pathogens that lead to issues like BV and UTIs. Also known as: The next frontier in vaginal health.
Our bodies are home to multiple microbiomes, from the gut microbiome to the skin microbiome to the axillary microbiome (within our armpits).8 Some organisms can be found in multiple biomes, while others tend to stick to a specific region.9 The moist, humid conditions of the vaginal canal have attracted unique microscopic residents over the lengthy course of human-microbe coevolution.10
While this vaginal microbiome (VMB) is a busy bacterial hub, it tends to have less diversity than other biomes of the body like the gut microbiome.1,11 In a peak state of equilibrium, vaginal microbiotas are dominated by the genus Lactobacillus.
Lactobacillus help keep your vagina healthy and comfortable:
Lactobacillus bacteria produce all-important lactic acid, which helps maintain a moderately acidic environment in the vagina (typically at a pH level between 3.8—5.0 during reproductive years).1,12
You might associate acidity with decay and corrosion, but in the vaginal microbiome’s case, it’s a really good thing. A more acidic microenvironment has a suppressive effect on disruptive bacteria that can lead to issues like bacterial vaginosis (BV), urinary tract infections (UTIs), and yeast infections.13 More acidic VMBs also tend to be more resilient against other infections, like STIs.
Vaginal discharge—a combination of cervical mucus, bacteria, dead cells from the vaginal epithelium, and vaginal fluid—also creates an environment for beneficial bacteria to thrive.12,14 (Yep, seeing discharge in your underwear is totally normal and not at all “gross.”)
But not all Lactobacillus are created equal:
Acidity-regulating lactobacilli are considered a “keystone species” (a species that other organisms in an ecosystem depend on for life) for the vaginal ecosystem—but there is immense variety within this one bacterial family.
Within the larger Lactobacillus genus, there are hundreds of species with characteristics that are distinct from other bacterial groups.15 (And within those species, there are also subsets of strains that share certain genetic information—see where this gets as mind-boggling as ocean exploration now?).
Some species, like Lactobacillus crispatus, appear to offer a heightened level of protection thanks to strains that produce bacteriocins.1,13 These help defend vaginal walls and cell tissues against disease-carrying microbes, and help Lactobacillus species to establish themselves and survive.17
Other types of Lactobacillus species, like Lactobacillus iners, don’t offer the same protection and seem to be more vulnerable to disruption.18,19
Ideally, your vagina is teeming with microbes that keep predators at bay and filter out threats in real-time.20
Definitions
Bacteriocins, Lactobacillus
Definitions
Bacteriocins: Molecules that neutralize pathogens. Bacteriocins have targeted, naturally occurring antibiotic (killing the bad guys) and probiotic (feeding the good ones) functions that help prevent “dysbiosis” or disorder.16
Lactobacillus: A genus of bacteria that produce lactic acid as a byproduct of fermentation. Some types of Lactobacillus, such as Lactobacillus crispatus, have been shown to help promote a stronger and more resilient vaginal microbiome.
Research suggests that most (but not all) vaginal microbiomes are dominated by one Lactobacillus species.1
However, exhaustive sequencing shows that no two vaginal microbiomes are the same—though they can be generally categorized into five “groups” that share similar characteristics and themes. First established by Jacques Ravel, Ph.D., a leading expert in vaginal microbiome science, these five Community State Types (CSTs) of the vaginal microbiome are:21
CST I — Lactobacillus crispatus dominant
CST I, dominated by Lactobacillus crispatus, produces high levels of lactic acid and appears to be most resistant to BV, STIs, and other vaginal infections, as well as protective against preterm birth.22,23,24,25,26,27 You could say it’s the holy grail of VMBs, and it’s found in about 10% of women.28
CST II — Lactobacillus gasseri dominant
Lactobacillus gasseri dominates CST II, which is a relatively rare CST that seems to be less stable and protective than CST I.1,26
CST V — Lactobacillus jensenii dominant
Lactobacillus jensenii rules in this domain, and it seems to promote a vaginal ecosystem that is acidic with a low chance of dysbiosis.21,29 Like CST II, CST V is relatively rare and not quite as protective as CST I.21
CST III — Lactobacillus iners dominant
Lactobacillus iners takes center stage within CST III, one of the most common VMB states.21 This somewhat fickle strain is not solidly categorized as either harmful or beneficial—it can swing either way.30 All in all, CST III seems to offer less protection against dysbiosis and be more prone to disruption than other Lactobacillus types.18,19
CST IV — Non Lactobacillus dominated
You can think of this CST as the chaos category. It’s not dominated by a Lactobacillus species. Instead, it’s governed by a more diverse array of bacteria that might include Atopobium, Prevotella, or Gardnerella.4
While having this type doesn’t necessarily mean you have an active vaginal infection (or even vaginal symptoms), CST IV has been linked to a higher likelihood of several health conditions, including BV, STIs, as well as infertility, and preterm birth.4,31,32,33
EXPLORE FURTHER: Describing The 5 Types of Vaginal Microbiomes
Definitions
Community State Type
Definitions
Community State Type: A grouping system used to define the five vaginal microbiome types that have been identified in research led by Jacques Ravel, Ph.D.
The latest science shows that CSTs are fluid, rather than static. Your CST might change at certain points of your menstrual cycle, for example, since lactobacilli abundance tends to drop and vaginal pH creeps up slightly during your cycle.12,34 Your age, pregnancy status, and lifestyle habits (including sexual activity) can influence your VMB makeup, too, potentially shifting it in or out of dysbiosis.35
While some change is to be expected, people who switch between CSTs more rapidly (spending less than 2-3 weeks in one CST) seem to be more prone to dysbiosis, according to some research.36
This means that reductionist terms such as “healthy” and “unhealthy” or “good” and “bad” just aren’t fit to describe the vaginal microbiome. It’s too versatile for that. Instead, healthy or not, balanced or not, will look different from one VMB to the next. Just like its host (you!), the vaginal microbiome is complex and ever-evolving.
EXPLORE FURTHER: How Your Vaginal Microbiome Shifts Throughout Your Life
Ideally, your vagina is teeming with microbes that keep predators at bay and filter out threats in real-time.
Since the vaginal environment is far from fixed, there are plenty of things you can do to shape yours. Taking daily steps to keep beneficial bacteria in and harmful pathogens out—from only using antibiotics as needed to managing stress to using protection during sex to avoiding douching—will be a great first line of defense.
And for the approximately 5-9% of women who suffer from recurring (at least 3 per year) vaginal infections, “just deal with it” hopefully won’t be the default advice for much longer.37 As vaginal probiotics become more meticulously designed, some are starting to include L. crispatus bacterial strains that have been clinically shown to restore a healthy balance of vaginal microflora.
In the future, vaginal microbiome transplants, could also be a viable option for some.38 A 2023 proof-of-concept case study transplanted vaginal fluid into a woman who suffered from vaginal irritation and a complicated pregnancy history.39 Her VMB went from being 90% dominated by Gardnerella species to being 81.2% L. crispatus and 9% L. jensenii dominated after the procedure. Five months after the transplant, she became pregnant and went on to deliver a healthy baby at term.
Definitions
Vaginal microbiome transplant
Definitions
Vaginal microbiome transplants: Procedures that transfer vaginal fluid from a healthy host to a patient with dysbiosis.
The vaginal microbiome is an ecosystem of bacteria, fungi, and other microscopic organisms that help protect the vaginal environment from pathogens that lead to issues like BV and UTIs. Research shows that this microbiome is constantly changing. Practicing safe sex, avoiding disruptive practices like douching, and taking a science-backed vaginal probiotic are a few ways to ensure your vaginal microbiome stays strong and resilient.
We predict that the VMB is the next frontier of vaginal healthcare. It’s all within reach: increased prevention, highly personalized care, and more effective treatments for symptoms we used to think just “came with the territory” of having a vagina.
Here’s to entering a new era of exploration—this time, into the depths of the landscapes within.
- France, M., Alizadeh, M., Brown, S. E., Ma, B., & Ravel, J. (2022). Towards a deeper understanding of the vaginal microbiota. Nature Microbiology, 7(3), 367–378. https://doi.org/10.1038/s41564-022-01083-2
- Willems, H. M. E., Ahmed, S. S., Liu, J., Xu, Z., & Peters, B. M. (2020). Vulvovaginal candidiasis: A current understanding and burning questions. Journal of Fungi (Basel, Switzerland), 6(1), 27. https://doi.org/10.3390/jof6010027
- Stapleton, A. E. (2016). The vaginal microbiota and urinary tract infection. Microbiology Spectrum, 4(6). https://doi.org/10.1128/microbiolspec.uti-0025-2016
- Gajer, P., Brotman, R. M., Bai, G., Sakamoto, J., Schütte, U. M., Zhong, X., Koenig, S. S., Fu, L., Ma, Z. S., Zhou, X., Abdo, Z., Forney, L. J., & Ravel, J. (2012). Temporal dynamics of the human vaginal microbiota. Science Translational Medicine, 4(132), 132ra52. https://doi.org/10.1126/scitranslmed.3003605
- Ravel, J., Moreno, I., & Simón, C. (2021b). Bacterial vaginosis and its association with infertility, endometritis, and pelvic inflammatory disease. American Journal of Obstetrics and Gynecology, 224(3), 251–257. https://doi.org/10.1016/j.ajog.2020.10.019
- Saadaoui, M., Singh, P., Ortashi, O., & Al Khodor, S. (2023). Role of the vaginal microbiome in miscarriage: Exploring the relationship. Frontiers in Cellular and Infection Microbiology, 13, 1232825. https://doi.org/10.3389/fcimb.2023.1232825
- Champer, M., Wong, A. M., Champer, J., Brito, I., Messer, P. W., Hou, J. Y., & Wright, J. D. (2017). The role of the vaginal microbiome in gynaecological cancer. BJOG, 125(3), 309–315. https://doi.org/10.1111/1471-0528.14631
- James, A. G. (2020). The axillary microbiome and its relationship with underarm odor. In Skin Microbiome Handbook: From Basic Research to Product Development (pp. 79–129). https://doi.org/10.1002/9781119593058.ch5
- Dekaboruah, E., Suryavanshi, M. V., Chettri, D., & Verma, A. K. (2020). Human microbiome: An academic update on human body site specific surveillance and its possible role. Archives of Microbiology, 202(8), 2147–2167. https://doi.org/10.1007/s00203-020-01931-x
- Chen, X., Lu, Y., Chen, T., & Li, R. (2021). The female vaginal microbiome in health and bacterial vaginosis. Frontiers in Cellular and Infection Microbiology, 11. https://doi.org/10.3389/fcimb.2021.631972
- Rinninella, E., Raoul, P., Cintoni, M., Franceschi, F., Miggiano, G. A. D., Gasbarrini, A., & Mele, M. C. (2019). What is the healthy gut microbiota composition? A changing ecosystem across age, environment, diet, and diseases. Microorganisms, 7(1), 14. https://doi.org/10.3390/microorganisms7010014
- Lin, Y. P., Chen, W. C., Cheng, C. M., & Shen, C. J. (2021). Vaginal pH value for clinical diagnosis and treatment of common vaginitis. Diagnostics (Basel, Switzerland), 11(11), 1996. https://doi.org/10.3390/diagnostics11111996
- Amabebe, E., & Anumba, D. (2018). The vaginal microenvironment: The physiologic role of lactobacilli. Frontiers in Medicine, 5. https://doi.org/10.3389/fmed.2018.00181
- Ventolini, G., Gandhi, K., Manales, N. J., Garza, J., Sanchez, A., & Martinez, B. (2022). Challenging vaginal discharge, Lactobacillosis and cytolytic vaginitis. Journal of Family & Reproductive Health, 16(2), 102–105. https://doi.org/10.18502/jfrh.v16i2.9477
- Zheng, J., Wittouck, S., Salvetti, E., Franz, C. M. A. P., Harris, H. M. B., Mattarelli, P., O’Toole, P. W., Pot, B., Vandamme, P., Walter, J., Watanabe, K., Wuyts, S., Felis, G. E., Gänzle, M. G., & Lebeer, S. (2020). A taxonomic note on the genus Lactobacillus: Description of 23 novel genera, emended description of the genus Lactobacillus Beijerinck 1901, and union of Lactobacillaceae and Leuconostocaceae. International Journal of Systematic and Evolutionary Microbiology, 70(4), 2782–2858. https://doi.org/10.1099/ijsem.0.004107
- Gillor, O., Etzion, A., & Riley, M. A. (2008). The dual role of bacteriocins as anti- and probiotics. Applied Microbiology and Biotechnology, 81(4), 591–606. https://doi.org/10.1007/s00253-008-1726-5
- Maldonado-Barragán, A., Caballero-Guerrero, B., Martín, V., Ruiz-Barba, J. L., & Rodríguez, J. M. (2016). Purification and genetic characterization of gassericin E, a novel co-culture inducible bacteriocin from Lactobacillus gasseri EV1461 isolated from the vagina of a healthy woman. BMC Microbiology, 16, 37. https://doi.org/10.1186/s12866-016-0663-1
- Zheng, N., Guo, R., Wang, J., Zhou, W., & Ling, Z. (2021). Contribution of Lactobacillus iners to vaginal health and diseases: A systematic review. Frontiers in Cellular and Infection Microbiology, 11. https://doi.org/10.3389/fcimb.2021.792787
- Verstraelen, H., Verhelst, R., Claeys, G., De Backer, E., Temmerman, M., & Vaneechoutte, M. (2009). Longitudinal analysis of the vaginal microflora in pregnancy suggests that L. crispatus promotes the stability of the normal vaginal microflora and that L. gasseri and/or L. iners are more conducive to the occurrence of abnormal vaginal microflora. BMC Microbiology, 9(1), 116. https://doi.org/10.1186/1471-2180-9-116
- Huang, B., Fettweis, J. M., Brooks, J. P., Jefferson, K. K., & Buck, G. A. (2014). The changing landscape of the vaginal microbiome. Clinics in Laboratory Medicine, 34(4), 747–761. https://doi.org/10.1016/j.cll.2014.08.006
- Ravel, J., Gajer, P., Abdo, Z., Schneider, G., Koenig, S., McCulle, S. L., Karlebach, S., Gorle, R., St Clair Russell, J., Tacket, C. O., Brotman, R. M., Davis, C., Ault, K. A., Peralta, L., & Forney, L. J. (2010). Vaginal microbiome of reproductive-age women. Proceedings of the National Academy of Sciences of the United States of America, 108(supplement_1), 4680–4687. https://doi.org/10.1073/pnas.1002611107
- Abdelmaksoud, A. A., Koparde, V. N., Sheth, N. U., Serrano, M. G., Glascock, A. L., Fettweis, J. M., Strauss, J. F., Buck, G. A., & Jefferson, K. K. (2016). Comparison of Lactobacillus crispatus isolates from Lactobacillus-dominated vaginal microbiomes with isolates from microbiomes containing bacterial vaginosis-associated bacteria. Microbiology (Reading, England), 162(3), 466–475. https://doi.org/10.1099/mic.0.000238
- Srinivasan, S., & Fredricks, D. N. (2008). The human vaginal bacterial biota and bacterial vaginosis. Interdisciplinary Perspectives on Infectious Diseases, 2008, 750479. https://doi.org/10.1155/2008/750479
- Nardini, P., Palomino, R. a. Ñ., Parolin, C., Laghi, L., Foschi, C., Cevenini, R., Vitali, B., & Marangoni, A. (2016). Lactobacillus crispatus inhibits the infectivity of Chlamydia trachomatis elementary bodies, in vitro study. Scientific Reports, 6(1). https://doi.org/10.1038/srep29024
- Lewis, F. M. T., Bernstein, K. T., & Aral, S. O. (2017). Vaginal microbiome and its relationship to behavior, sexual health, and sexually transmitted diseases. Obstetrics and Gynecology, 129(4), 643–654. https://doi.org/10.1097/aog.0000000000001932
- Wu, S., Hugerth, L. W., Schuppe-Koistinen, I., & Du, J. (2022). The right bug in the right place: Opportunities for bacterial vaginosis treatment. NPJ Biofilms and Microbiomes, 8(1), 34. https://doi.org/10.1038/s41522-022-00295-y
- Bayar, E., Bennett, P. R., Chan, D., Sykes, L., & MacIntyre, D. A. (2020). The pregnancy microbiome and preterm birth. Seminars in Immunopathology, 42(4), 487–499. https://doi.org/10.1007/s00281-020-00817-w
- Ravel, J. (2024) Disruption and stability of the vaginal microbiome: A data-driven approach [White Paper] Med-Lock Health
- France, M., Ma, B., Gajer, P., Brown, S. E., Humphrys, M. S., Holm, J. B., Waetjen, L. E., Brotman, R. M., & Ravel, J. (2020). VALENCIA: a nearest centroid classification method for vaginal microbial communities based on composition. Microbiome, 8(1). https://doi.org/10.1186/s40168-020-00934-6
- Petrova, M. I., Reid, G., Vaneechoutte, M., & Lebeer, S. (2017). Lactobacillus iners: Friend or foe?. Trends in Microbiology, 25(3), 182–191. https://doi.org/10.1016/j.tim.2016.11.007
- Forney, L. J., Foster, J. A., & Ledger, W. (2006). The vaginal flora of healthy women is not always dominated byLactobacillusSpecies. The Journal of Infectious Diseases, 194(10), 1468–1469. https://doi.org/10.1086/508497
- Mania‐Pramanik, J., Kerkar, S., & Salvi, V. (2009). Bacterial vaginosis: A cause of infertility? International Journal of STD & AIDS, 20(11), 778–781. https://doi.org/10.1258/ijsa.2009.009193
- Fettweis, J. M., Serrano, M. G., Brooks, J. P., Edwards, D. J., Girerd, P. H., Parikh, H. I., Huang, B., Arodz, T. J., Edupuganti, L., Glascock, A. L., Xu, J., Jimenez, N. R., Vivadelli, S. C., Fong, S. S., Sheth, N. U., Jean, S., Lee, V., Bokhari, Y. A., Lara, A. M., Mistry, S. D., … Buck, G. A. (2019). The vaginal microbiome and preterm birth. Nature medicine, 25(6), 1012–1021. https://doi.org/10.1038/s41591-019-0450-2
- Oerlemans, E., Ahannach, S., Wittouck, S., Dehay, E., De Boeck, I., Ballet, N., Rodriguez, B., Tuyaerts, I., & Lebeer, S. (2022). Impacts of menstruation, community type, and an oral yeast probiotic on the vaginal microbiome. MSphere, 7(5), e0023922. https://doi.org/10.1128/msphere.00239-22
- Song, S., Acharya, K. D., Zhu, J. E., Deveney, C. M., Walther-António, M., Tetel, M. J., & Chia, N. (2020). Daily vaginal microbiota fluctuations associated with natural hormonal cycle, contraceptives, diet, and exercise. MSphere, 5(4). https://doi.org/10.1128/msphere.00593-20
- Brooks, J. P., Buck, G. A., Chen, G., Diao, L., Edwards, D., Fettweis, J. M., Huzurbazar, S., Rakitin, A. Y., Satten, G. A., Smirnova, E., Waks, Z., Wright, M. L., Yanover, C., & Zhou, Y. (2017). Changes in vaginal community state types reflect major shifts in the microbiome. Microbial Ecology in Health and Disease, 28(1), 1303265. https://doi.org/10.1080/16512235.2017.1303265
- Benedict, K., Singleton, A. L., Jackson, B. R., & Molinari, N. A. M. (2022). Survey of incidence, lifetime prevalence, and treatment of self-reported vulvovaginal candidiasis, United States, 2020. BMC Women’s Health, 22(1), 147. https://doi.org/10.1186/s12905-022-01741-x
- Lev‐Sagie, A., Goldman‐Wohl, D., Cohen, Y., Dori-Bachash, M., Leshem, A., Mor, U., Strahilevitz, J., Moses, A. E., Shapiro, H., Yagel, S., & Elinav, E. (2019). Vaginal microbiome transplantation in women with intractable bacterial vaginosis. Nature Medicine, 25(10), 1500–1504. https://doi.org/10.1038/s41591-019-0600-6
- Wrønding, T., Vomstein, K., Bosma, E. F., Mortensen, B. O. G., Westh, H., Heintz, J., Mollerup, S., Petersen, A. M., Ensign, L. M., DeLong, K., Van Hylckama Vlieg, J. E. T., Thomsen, A. B., & Nielsen, H. S. (2023). Antibiotic-free vaginal microbiota transplant with donor engraftment, dysbiosis resolution and live birth after recurrent pregnancy loss: A proof of concept case study. EClinicalMedicine, 61, 102070. https://doi.org/10.1016/j.eclinm.2023.102070


















